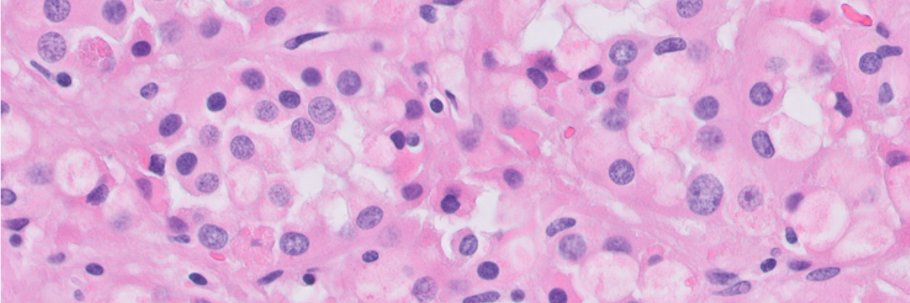
Cornelia Ding, MD, PhD banner

#PCFRetreat25 @PCF_Science
Prostate Laser Ablation Yielding Directed Optimal Healing: "Play-Doh" therapy


English
Cornelia Ding, MD, PhD
54 posts

@ckcding
Uropathologist @ UCSF / enjoy choral singing and science / originally from Taiwan





Falcon 9 lifts off from pad 4E in California, delivering 23 @Starlink satellites to the constellation

THRILLED to announce @LotanLab 5th Director of Research @brady_urology in footsteps of Don Coffey to transform care & mentor leaders! 1st woman to hold position. Dr. Pienta to serve as Special Advisor to Provost & advance to Director Innovation and Strategy! CONGRATULATIONS!































